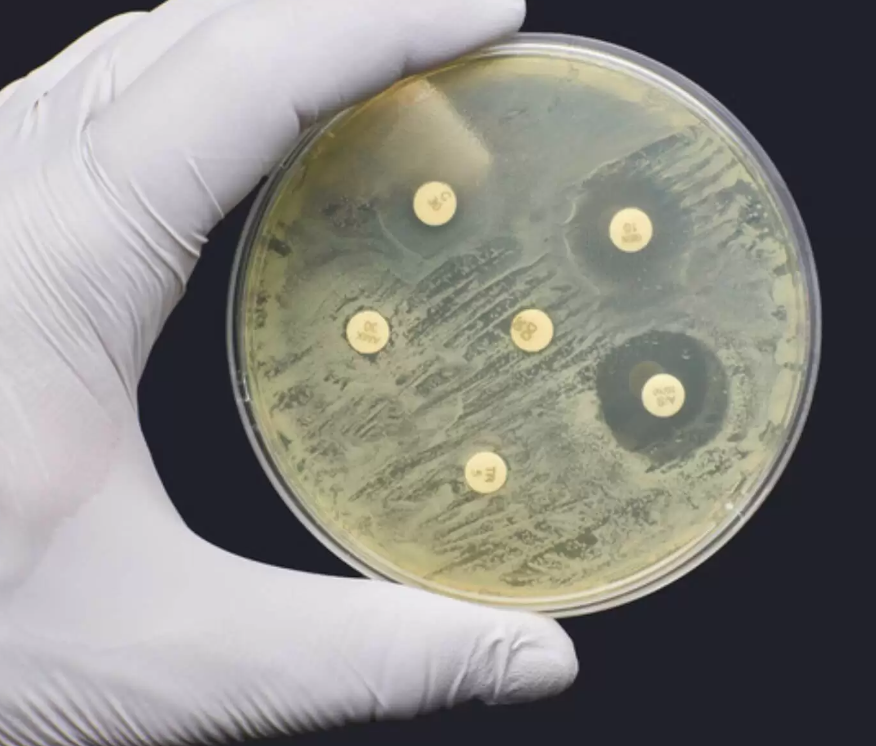

كشفت دراسة حديثة عن ارتفاع كبير في مقاومة Salmonella Typhi للمضاد الحيوي (Ciprofloxacin)، حيث بلغت نسب المقاومة أكثر من 90% في بعض العينات الهندية. وترتبط هذه الظاهرة بطفرات في الجينات gyrA وparC، التي تُضعف فعالية الدواء. كما لوحظت مقاومة مرافقة لمضادات مثل (Nalidixic Acid). وأوصت الدراسة باللجوء إلى بدائل علاجية أكثر فاعلية، مثل (Ceftriaxone) و (Piperacillin/Tazobactam)، إلى جانب اعتماد تقنيات تشخيص دقيقة كـ PCR والتصوير فوق الصوتي.
شروط النشر
• نلفت عناية المشاركين الأعزاء الى :
- تُحظرُ المنشورات المسيئة للأديان والرموز المقدسة .
- تُحظرُ المنشورات المتضمنة لألفاظٍ خادشةٍ للآداب والذوق العام .
- تُحظرُ المنشورات المُحرّضة على العنف وإذكاء النعرات .
- قبل إرسالكَ المنشور ، تذكّر قوله تعالى : (مَا يَلْفِظُ مِنْ قَوْلٍ إِلَّا لَدَيْهِ رَقِيبٌ عَتِيدٌ)
- تُحظرُ المنشورات المسيئة للأديان والرموز المقدسة .
- تُحظرُ المنشورات المتضمنة لألفاظٍ خادشةٍ للآداب والذوق العام .
- تُحظرُ المنشورات المُحرّضة على العنف وإذكاء النعرات .
- قبل إرسالكَ المنشور ، تذكّر قوله تعالى : (مَا يَلْفِظُ مِنْ قَوْلٍ إِلَّا لَدَيْهِ رَقِيبٌ عَتِيدٌ)
اخر التعليقات
| وتؤكد النتائج ضرورة مراجعة بروتوكولات علاج |  |
|
|
| يتضمن التدبير العلاجي إعطاء مضادات |  |
|
|
| أما الاختبار غير المباشر، فيهدف إلى الكشف |  |
|
|
| صافي الأصول الأجنبية لأي دولة هو قيمة |  |
|
|
| لم تعرف الأُمّة إلا مَن رحم الله تعالى حقَّ |  |
|
|
اخر المسجلين في الصفحة
أخترنا لكم
تحذيرات عقلية (5): إيّاك أن تقول: (عقلي يقول)، والعقل
المزيد 








